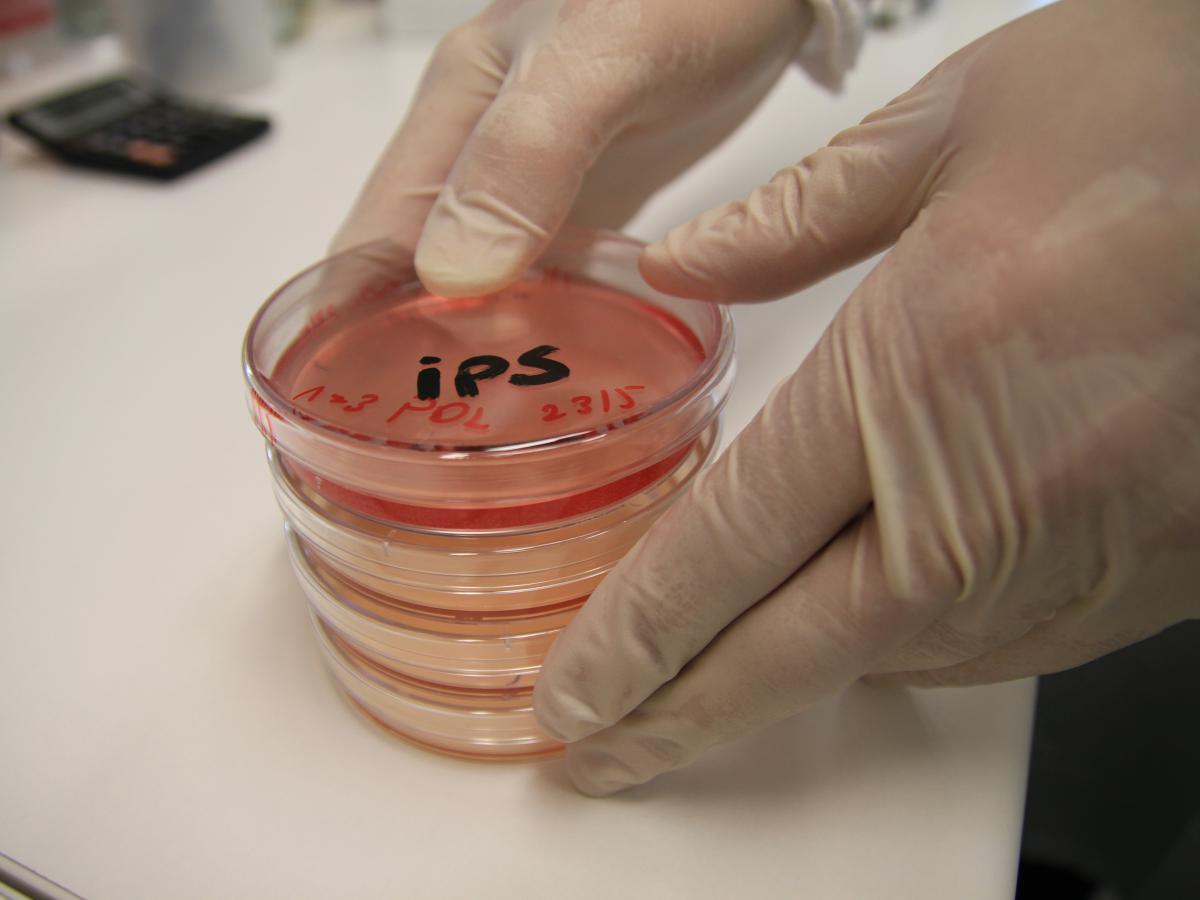
Паразит? Нет — бесплатная еда: наш иммунитет научился использовать врагов с выгодой

Паразит? Нет — бесплатная еда: наш иммунитет научился использовать врагов с выгодой
В новом исследовании, опубликованном в журнале Nature в феврале 2025 года, показано, что макрофаги после фагоцитирования патогенов не просто уничтожают их, а также ассимилируют.
То есть они переваривают бактерии и используют их компоненты — углерод, азот, аминокислоты — как источник питательных веществ, которые включаются в их метаболические пути. Таким образом, иммунная система не только борется с врагами, но и "питается" ими.
Это меняет классические представления о границе между угрозой и пищей. Макрофаги не выбирают между уничтожением и питанием, а превращают опасность в источник ресурсов для своего выживания и функционирования. Этот процесс касается как живых, так и мертвых бактерий — в обоих случаях молекулы перерабатываются и используются для поддержки ресурсов макрофага.